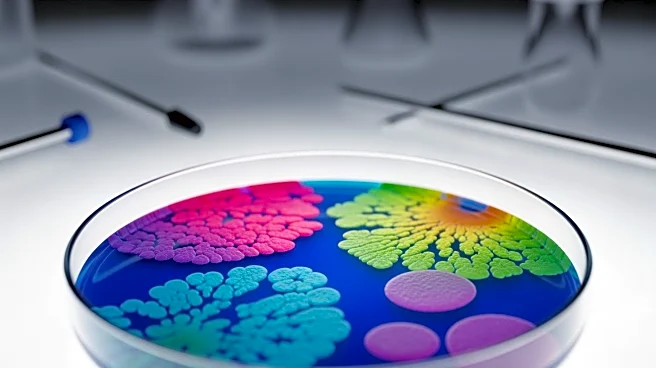
University of Utah Research Identifies Gut Bacteria That Reduces Weight Gain in Mice

What's Happening?
Sidney Crosby has officially surpassed Mario Lemieux to become the all-time points leader for the Pittsburgh Penguins, achieving a total of 1,724 points. This milestone was reached during a recent game, marking a significant achievement in Crosby's career. The NHL Network's 'NHL Now' highlighted this accomplishment, emphasizing Crosby's impact on the team and the league. The Penguins' recent activities also include the launch of 'Little Free Libraries' in partnership with U.S. Steel, aimed at promoting literacy in the Pittsburgh area. Additionally, the team faces a challenge with the injury of Tristan Jarry, who is expected to be out for several weeks.
Why It's Important?
Crosby's achievement as the Penguins' all-time points leader underscores his exceptional talent
and contribution to the team. This record not only enhances his personal legacy but also elevates the status of the Pittsburgh Penguins within the NHL. The 'Little Free Libraries' initiative reflects the team's dedication to community service and education, potentially inspiring other sports organizations to engage in similar efforts. Tristan Jarry's injury presents a challenge for the Penguins, as they will need to adapt their gameplay and possibly rely on other players to fill the gap.
What's Next?
The Pittsburgh Penguins will focus on maintaining their momentum following Crosby's record-breaking performance. The team will need to strategize around Jarry's absence, possibly exploring options for temporary replacements or adjustments in their lineup. The 'Little Free Libraries' project is expected to grow, contributing to community development and literacy. Fans and analysts will be keen to observe how Crosby continues to lead the team and how the Penguins navigate the challenges posed by Jarry's injury.